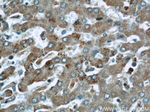
ABHD5 Antibody in Immunohistochemistry (Paraffin) (IHC (P))
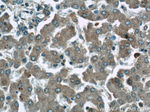
ABHD5 Antibody in Immunohistochemistry (Paraffin) (IHC (P))

Search
Proteintech
ABHD5 Polyclonal Antibody
{{$productOrderCtrl.translations['antibody.pdp.commerceCard.promotion.promotions']}}
{{$productOrderCtrl.translations['antibody.pdp.commerceCard.promotion.viewpromo']}}
{{$productOrderCtrl.translations['antibody.pdp.commerceCard.promotion.promocode']}}: {{promo.promoCode}} {{promo.promoTitle}} {{promo.promoDescription}}. {{$productOrderCtrl.translations['antibody.pdp.commerceCard.promotion.learnmore']}}
产品信息
12201-1-AP
种属反应
已发表种属
宿主/亚型
分类
类型
抗原
偶联物
形式
浓度
规格
纯化类型
保存液
内含物
保存条件
运输条件
产品详细信息
Immunogen sequence: EEVDSADTG ERSGWLTGWL PTWCPTSISH LKEAEEKMLK CVPCTYKKEP VRISNGNKIW TLKFSHNISN KTPLVLLHGF GGGLGLWALN FGDLCTNRPV YAFDLLGFGR SSRPRFDSDA EEVENQFVES IEEWRCALGL DKMILLGHNL GGFLAAAYSL KYPSRVNHLI LVEPWGFPER PDLADQDRPI PVWIRALGAA LTPFNPLAGL RIAGPFGLSL VQRLRPDFKR KYSSMFEDDT VTEYIYHCNV QTPSGETAFK NMTIPYGWAK RPMLQRIGKM HPDIPVSVIF GARSCIDGNS GTSIQSLRPH SYVKTIAILG AGHYVYADQP EEFNQKVKEI CDTVD (6-349 aa encoded by BC021958)
靶标信息
The protein encoded by this gene belongs to a large family of proteins defined by an alpha/beta hydrolase fold, and contains three sequence motifs that correspond to a catalytic triad found in the esterase/lipase/thioesterase subfamily. It differs from other members of this subfamily in that its putative catalytic triad contains an asparagine instead of the serine residue. Mutations in this gene have been associated with Chanarin-Dorfman syndrome, a triglyceride storage disease with impaired long-chain fatty acid oxidation.
仅用于科研。不用于诊断过程。未经明确授权不得转售。
生物信息学
蛋白别名: 1-acylglycerol-3-phosphate O-acyltransferase ABHD5; Abhydrolase domain-containing protein 5; aCGI58; CGI 58; CGI58 protein; Lipid droplet-binding protein CGI-58; MGC8731; Protein CGI-58; unnamed protein product
基因别名: 1300003D03Rik; 2010002J10Rik; ABHD5; CDS; CGI-58; CGI58; IECN2; IECN5; NCIE2
UniProt ID: (Human) Q8WTS1, (Mouse) Q9DBL9
Entrez Gene ID: (Human) 51099, (Mouse) 67469